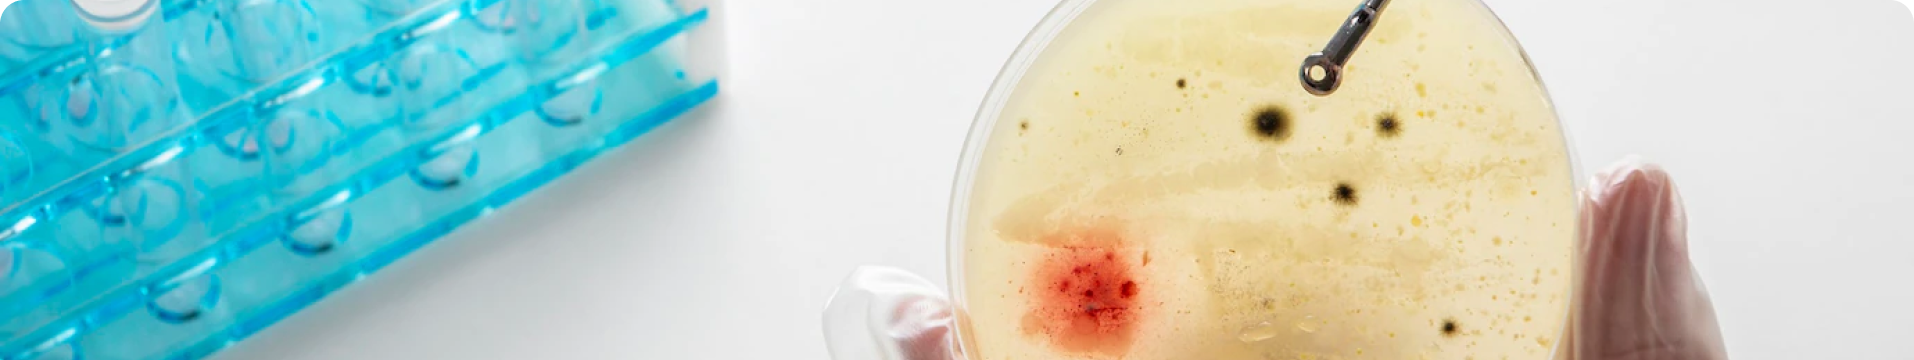
publication

An R Library to help researchers with the implementation of precision medicine in R

Discover Expertise: Explore our Published Books section for concise, authoritative works embodying our commitment to science and academia.

Explore Our Insights: Uncover a wealth of knowledge from our scientific publications, showcasing our contributions to diverse journals across a spectrum of industries

Dive into Knowledge: we curate transformative experiences and knowledge-sharing platforms, fostering collaboration and innovation in various topics.